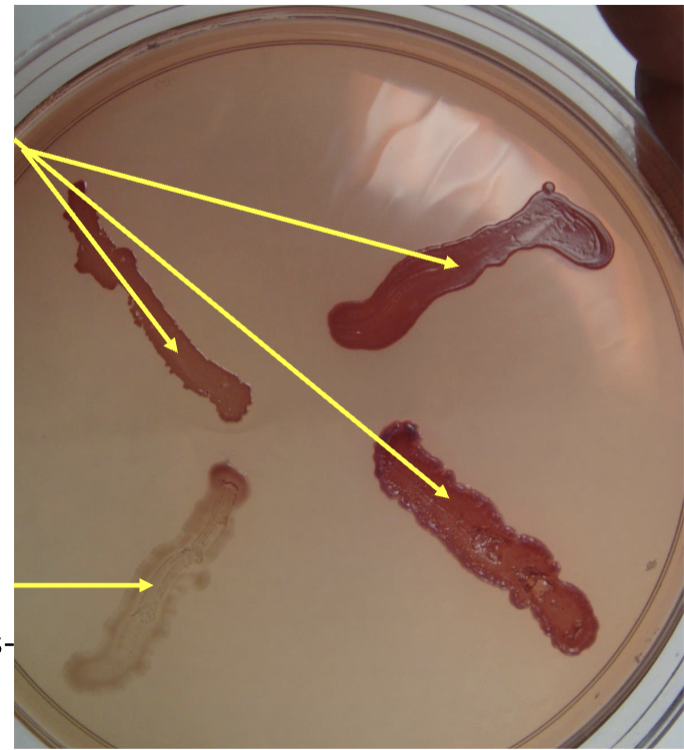
<p>what is the differential agent?- MAC</p>
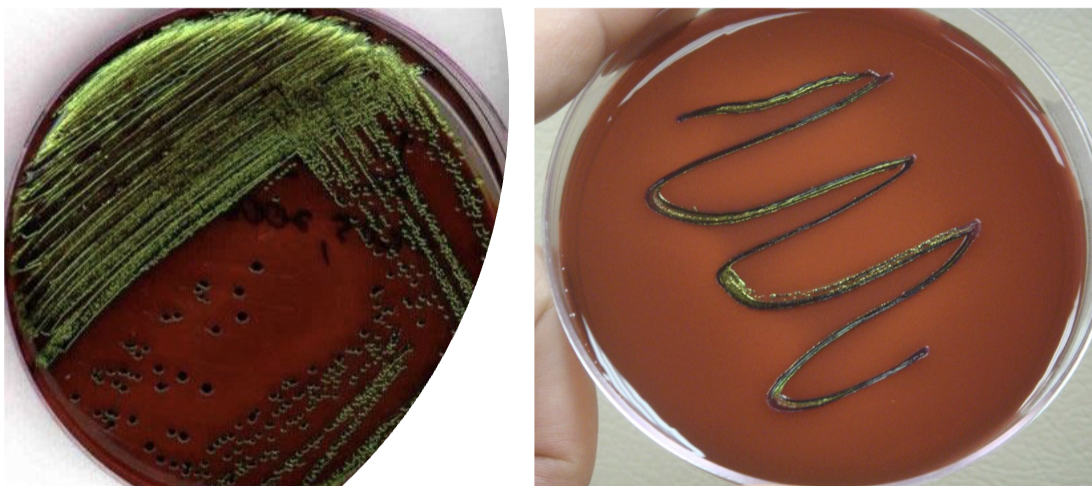
<p>if it’s green did it ferment lactose or not?</p>
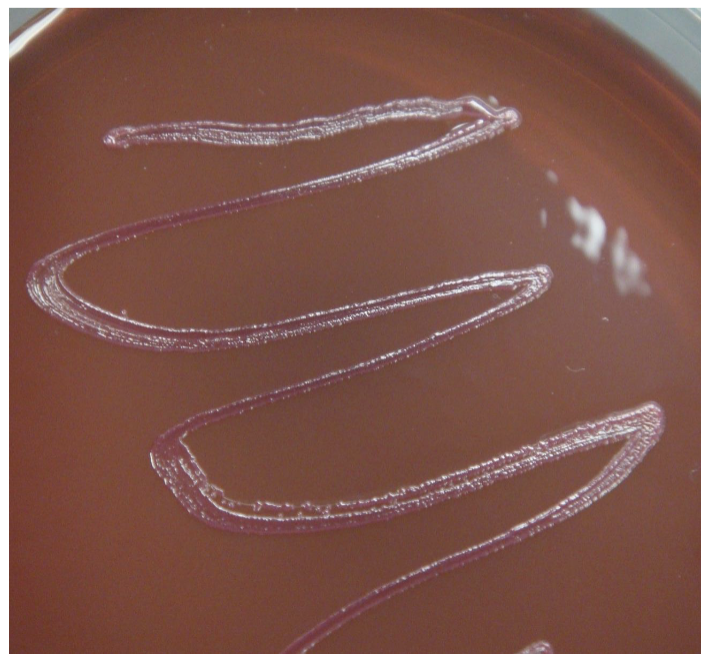
<p>pink/ red bacteria? EMB</p>
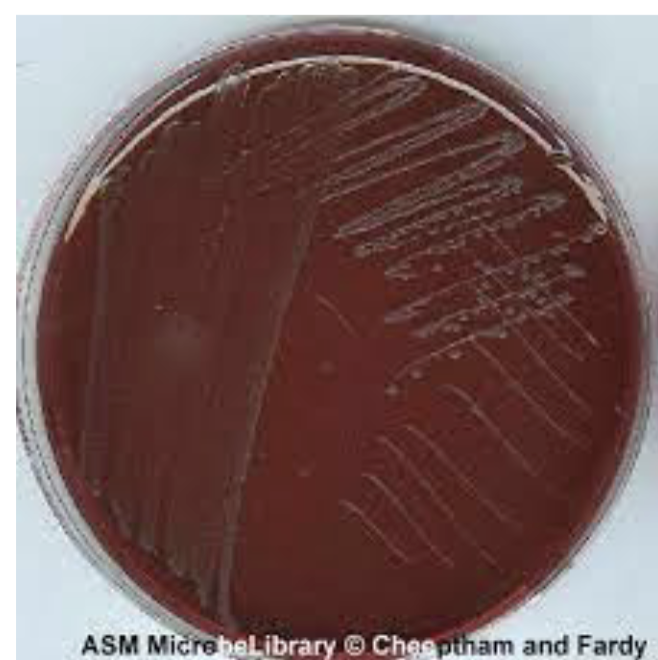
<p>whats this?</p>
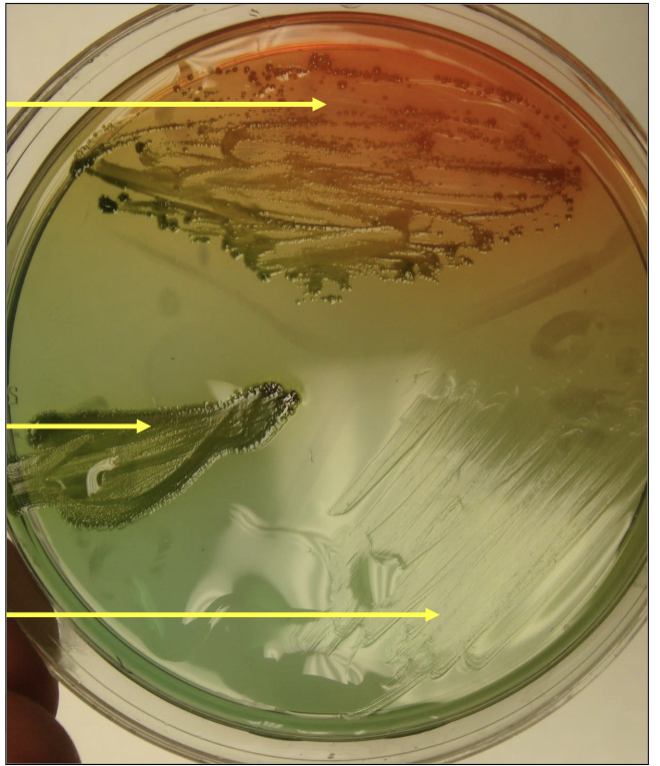
<p>what’s the ph indicator?</p>
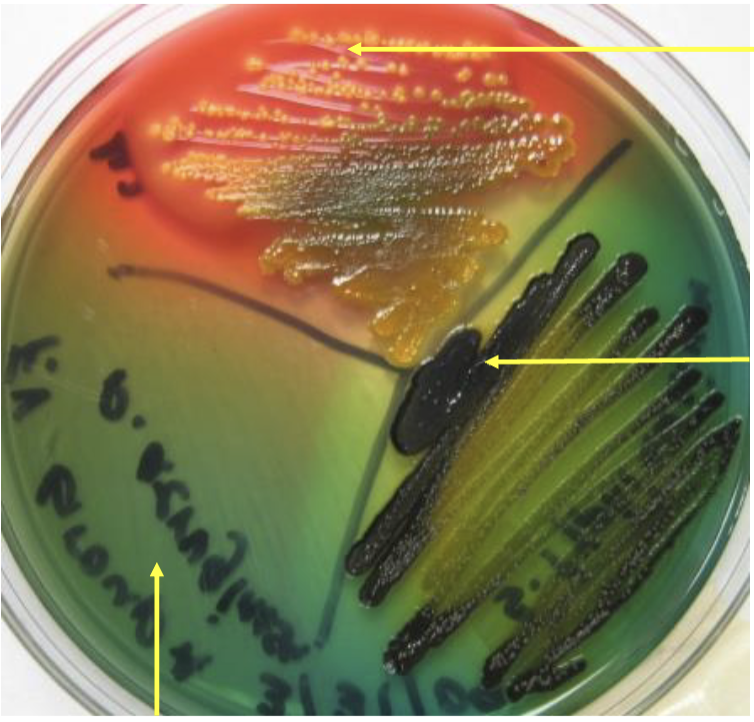
<p>whats the differential agent?…. and includes …., ….</p>

micro lab FINAL TEST NOW pt.1
1/77
There's no tags or description
Looks like no tags are added yet.
Name | Mastery | Learn | Test | Matching | Spaced | Call with Kai |
|---|
No analytics yet
Send a link to your students to track their progress
78 Terms

what is this?
MacConkey Agar

what is the ph indicator?
neutral red

what is it used for?
clinical samples

what type of agar is it?
selective and differential agar

what is the selective agents?
bile salts and crystal violet

what does it inhibits?
Gram positive bacteria
what is the differential agent?- MAC
lactose

why is it red? did it ferment lactose yes or no
it ferments lactose

why is it white?
does not ferment lactose

if its red is it + or -?
positive

name a positive bacteria that is red?
e.coli

name a bacteria that turn white?
Salmonella

if theres no growth its? + or -
Gram positive

what is this?
eosin methylene blue agar

does it have a ph indicator?
No

what is it used for?-emb
water samples

what type of agar?
selective and differential agar

what are the selective agents?
eosin, methylene blue, and crystal violet

who does it inhibit?
Gram positive

who grows?
gram negative bacteria

differential agent?
lactose
if it’s green did it ferment lactose or not?
fermented lactose

a bacteria that is green and fermented lactose is?
E.coli

if it’s pink or red did it ferment lactose or no? emb
it fermented lactose
pink/ red bacteria? EMB
enterobacter
whats this?
eosin methylene blue agar

what does it mean if it’s colorless but it still grows?
did it or did it not ferment lactose?
it does not ferment lactoses

what bacteria is colorless and doesn’t ferment lactose?EMB
salmonella

if there’s no growth its?
Gram positive bacteria

what’s this?
heckoin enteric agar
what’s the ph indicator?
bromothymol blue

what’s its used for?
for stool samples

what type of agar is this? HE
selective and differential agar

what are the selective agents?
bile salts

who does it inhibit?
Gram positive

who grows?
gram negative bacteria
whats the differential agent?…. and includes …., ….
Lactose and includes sucrose and salicin

what shows H2s production?
peptone iron

if it’s yellow orange did it ferment lactose or no ?
fermented lactose

what bacteriaq is it if it’s orange/ yellow?
e.coli

if it’s yellow’orange, black did it ferment lactose or no and did it produce h2s or no?
fermented lactose and produce h2s

what bacteria is it if it’s yellow/black?
citrobacter

if its the color of agar did it ferment or not lactose?
… …. …. … and bacteria name ….?
does not ferment lactose and alcaligenes

if it’s black its?… ….
h2s production

name a bacteria that has black production?
proteus

bottom arrow is what ? is there growth ?+ or -?
no growth, gram positive

what’s this?
oxidase test

what does it distuinguish?
non enteric gram positive bacteria and enteric gram negative bacteria

what does it test for? ….. ….. in …. …. ….. like ….
cytochrome oxidase in aerobic ETC pathway like mitochondria

reagent?
oxidase reagent

if its blue/ black color on swab its?
non enteric gram positive bacteria

if it’s not blue/black it’s?
enteric gram negative

if it’s blue/black what bacteria is it?
pseudomonas

if it’s not blue/black its what bacteria?
e.coli

what’s this?
decarboxylase test

what the top arrow pointing at?…. … it;s ….
mineral oil it’s anaerobic

what’s the ph indicator?
bromocresol purple

what are the substrate?
lysine, arginine, ornithine

what are the enzymes?
lysine decarboxylase, arginine decarboxylase, ornithine decarboxylase

product?
ammonia

what does the enzyme do? …. … … from … … making it ….
removes acid group from amino acid making it alkaline

if it’s purple with mineral oil its?
positive

if it’s yellow? + or - for…?
negative for decarboxylation

whos ORN decarboxylase positive?
enterobacter

who’s ARG decarboxylase positive?
salmonella

who’s LYS decarboxylase positive?
klebsiella

what’s this?
phenylalanine deaminase test

what’s the substrate?
phenylalanine

what’s the enzyme?
phenylalanine deaminase

what does the enzyme do?
removes amino group from phenylalanine into products

what are the products?
phenyl pyruvate and ammonia

what is the left side picture? color… with …. ….
green with ferric chloride

is the left picture + or - for ….. …..?
positive for phenyl pyruvate

left side bacteria GENUS name?
proteus

what are we testing for?
phenyl pyruvate

what’s right side picture?
yellow with ferric chloride

is it + or - for … …? right pic
negative for phenyl pyruvate

right side bacteria NAME?
e.coli